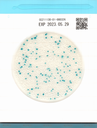
Easy Plate CC

Easy Plate CC
- 1 x 100 Placas/Pacote
Operação simples, resultados confiáveis - Certificação AOAC PTM
- Alta precisão
- Pronto para uso, coloque uma suspensão de amostra na placa e comece a incubação.
- Espaço de incubação muito pequeno e desperdício reduzido
Autodifusível, preciso e certificado (AOAC-PTM, NordVal, MicroVal). REDUZ o espaço, o tempo e o desperdício.
O Easy Plate CC é um dispositivo de cultura microbiológica composto por uma lâmina impermeável, um meio seco preparado na lâmina e uma tampa transparente sobre o meio. O método Easy Plate CC destina-se a indicar o nível de bactérias coliformes em produtos alimentícios como uma alternativa ao método de ágar vermelho-violeta biliar do Manual de Análise Bacteriológica da Food and Drug Administration (FDA BAM): Enumeração de Escherichia coli e Bactérias Coliformes. É compacto, fácil de usar e reduz a quantidade total de resíduos produzidos durante o teste. O método Easy Plate CC recebeu a certificação Performance Tested Methods SM do Instituto de Pesquisa AOAC (para carne de porco moída crua, cordeiro cru, frango moído cru, bife de atum cru, bife de salmão cru, camarão cru, banana-da-terra fresca descascada, abacaxi fresco cortado e maçãs frescas cortadas).
Durante a preparação das placas para incubação, não são necessárias ferramentas adicionais, devido ao anel hidrofóbico ao redor da área de cultura, que auxilia na dispersão automática da amostra na área de cultura.
1x100 Placas/Pacote
Microrganismos alvo: Coliformes
Número do artigo: 61974
Tempo de incubação: 24 horas ± 1 hora
Temperatura de incubação: 35 °C ± 1 °C
Prazo de validade: 18 meses após a fabricação
Armazenamento: 2-8 °C
Prepare a amostra de acordo com o manual.
Inocule 1 ml da solução da amostra com uma pipeta e abra a tampa da placa. Pipete a solução da amostra para a placa e feche a tampa.
Incube de acordo com o manual.
https://hyserv.sharepoint.com/:v:/s/Server/EeyU2zJ7ceJJkeQxGoG8NjQBPOcGieK7u9zhmZbmQC-L-g?e=hPABt8
- Easy Plate CC CC20260305A exp 04.09.2027.pdf
- Easy Plate CC CC20260206A exp 05.08.2027.pdf
- Easy Plate CC CC20260205A exp 04.08.2027.pdf
- Easy Plate CC CC20251202A exp 01.06.2027.pdf
- Easy Plate CC20251111A exp 10.05.2027.pdf
- Easy Plate CC CC20251007A exp 06.04.2027.pdf
- Easy Plate CC CC20250801A exp 31.01.2027.pdf
- Easy Plate CC CC20250310A exp 09.09.2026.pdf
- 61974_CC20250108A.pdf
- 61974_CC20250107A.pdf
- 61974_CC20250106A.pdf
- 61974_CC20241113A.pdf
- 61974_CC20241108A.pdf
- 61974_CC20240822A .pdf
- 61974_CC20240821A .pdf
- Easy Plate CC CC20240822A exp 21.02.2026 .pdf
- Easy Plate CC CC20240821A exp 20.02.2026 .pdf
- Easy Plate CC CC20240617A 16.12.2025.pdf
- Easy Plate CC CC20240613A exp 12.12.2025.pdf
- Easy Plate CC CC20240404A exp 03.10.2025.pdf
- Easy Plate CC - CC20240110A - exp 09.07.2025.pdf
- Easy Plate CC - CC20231208A - exp 07.06.2025.pdf
- Easy Plate CC - CC20231207A - exp 06.06.2025.pdf
- Easy Plate CC - CC20231120A - exp 19.05.2025.pdf
- Easy Plate CC - CC20231117A - exp 16.05.2025.pdf
- Easy Plate CC - CC20231018A - exp 17.04.2025.pdf
- Easy Plate CC - CC20230921A - exp 20.03.2025.pdf
- Easy Plate CC - CC20230919A - exp 18.03.2025.pdf
- Easy Plate CC - CC20230904A - exp 03.03.2025.pdf